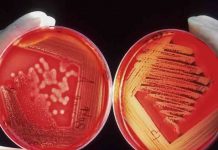
Ο λόγος που ο Candida Auris τρομάζει πολύ περισσότερο απ’ τον κορωνοϊό

Έφυγε από τη ζωή ο σπουδαίος μουσικός Βαγγέλης Παπαθανασίου
Θλίψη στον καλλιτεχνικό κόσμο προκαλεί η είδηση του θανάτου του Έλληνα μουσικού και συνθέτη, Βαγγέλη Παπαθανασίου. Σύμφωνα με όσα έχουν γίνει γνωστά, ο Έλληνας...
Πριν κατακτήσει την Ευρώπη, η Άιντραχτ διέλυσε τους φασίστες!
Η Άιντραχτ Φρανκφούρτης, η φετινή νικήτρια του Γιουρόπα Λιγκ δεν είναι απλά μια ομάδα, είναι η ομάδα που έδωσε κλωτσιά στους φασίστες! «Για όσο...
Καταρρίπτουμε τον «υπερμύθο» των superfoods
Η λέξη «Superfoods» είναι ευρέως διαδεδομένη και χρησιμοποιείται στο μάρκετινγκ των εξωτικών (και συνήθως ακριβών) φρούτων και λαχανικών. Αλλά τι ακριβώς κάνει ένα φαγητό...
18η Μαΐου: Διεθνής Ημέρα Μουσείων
Η 18η Μαΐου είναι αφιερωμένη κάθε χρόνο στα Μουσεία –τα οποία υποδέχονται το κοινό με δωρεάν είσοδο και σε ένα συγκεκριμένο θέμα που αφορά στην ανάδειξή...
Συγκλονιστική έρευνα για την τηλεργασία
Τα δύο τρίτα των εργαζομένων μπορεί να εγκαταλείψουν τη δουλειά τους και να προσπαθήσουν να βρουν καινούργια, εφόσον οι εργοδότες τους υποχρεώσουν σε φυσική...
Ο λόγος που ο Candida Auris τρομάζει πολύ περισσότερο απ’ τον κορωνοϊό
«Προκαλέσαμε τη σκοτεινή λίμνη». Με αυτή τη φράση έχουν υποδεχτεί στο παρελθόν οι επιστήμονες ανά τον κόσμο τις περιόδους έξαρσης του Candida Auris, ενός...
Ο Μελανσόν «πάει» για την πρωθυπουργία με ευρύτερη στήριξη της γαλλικής Αριστεράς
Τη στήριξη της ευρύτερης γαλλικής Αριστεράς έχει κι επισήμως ο Ζαν Λικ Μελανσόν, μετά και την οριστικοποίηση από πλευράς Σοσιαλιστικού Κόμματος της συμφωνίας με...
Το μεγάλο δίλημμα των κυρώσεων: Αντέχει η Ε.Ε. χωρίς ρωσική ενέργεια; – Τα υπέρ...
Έπειτα από σχεδόν έξι εβδομάδες πολέμου, τα κράτη μέλη της Ευρωπαϊκής Ένωσης εξακολουθούν να διαφωνούν για το εάν θα έπρεπε η όχι να επιβάλουν κυρώσεις κατά...
Έχετε αντιληφθεί τι συμβαίνει στις ΗΠΑ μετά την πανδημία;
Κατά τη διάρκεια της πανδημίας, ειδικά στις δύο πρώτες καραντίνες, σε πάρα πολλές πολιτείες των ΗΠΑ υπήρχε τεράστια αντίσταση κατά των κοινωνικών περιορισμών. Πρώτα...
Βαρθολομαίος: Αυτό που συμβαίνει στην Ουκρανία είναι μια τραγωδία
«Αυτό που συμβαίνει στην Ουκρανία είναι μια τραγωδία, είναι μια ντροπή που θα στιγματίζει εσαεί εκείνους που την προκάλεσαν, εκείνους που αποδείχθηκε ότι δεν έχουν φόβο...